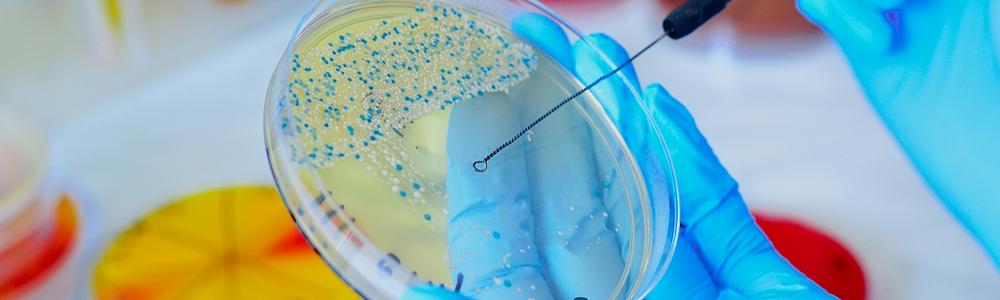
Händer som håller i en petriskål på labb.

Molecular Microbiology
Om utbildningen
This course in Molecular microbiology gives you in-depth knowledge and better understanding of the evolution, cell biology, genetics and molecular biology of microorganisms.
Specific subject areas included in the course are:
- Organization of the bacterial cell, metabolism and growth
- Replication of DNA, variation, evolution and gene expression
- Regulation of gene expression
- Cellular differentiation in prokaryotes
- Molecular mechanisms for different cellular processes
- Molecular biology of yeast fungi, Saccharomyces cerevisiae.
After completing the course, you will be able to
- present scientific literature to others
- apply your background knowledge to new topics
- plan an experiment and analyse results of experiments
- write in the format of a scientific paper
- perform a number of standard lab techniques, such as growth curves and genetic analysis.
Teaching
By taking this course, you are encouraged to actively participate in your education and therefore only a few lectures are held. In activities and seminars, you present and discuss important biological issues based on milestone research papers, reviews or other publications. The experimental work provides you with basic principles of microbiology and bacterial genetics. All students will work in small groups. Lab methods and results will be documented in lab reports.
This course is taught in English.
This course is open to
Exchange students at the Faculty of Science and exchange students on a university-wide agreement. Please contact your international coordinator at the University of Gothenburg if you need to know more.
In order to apply for this course you must have successfully completed basic courses in Biology 75 credits (BIO900 Cell Biology, BIO905 Molecular Genetics, BIO910 Biological form and function, BIO915 Ecology and Evolution and BIO920 Biodiversity and Systematics).
English proficiency
Incoming students should have an English level equivalent of B2 or higher as courses and materials, including presentations and exams, will be in English.
To assess your English level, you can use the self-assessment grid for reference: https://europa.eu/europass/en/common-european-framework-reference
Application
Do you want to apply for exchange studies at the University of Gothenburg?